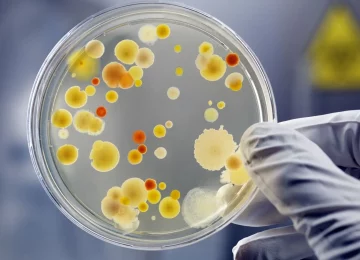
culture bacteries

La microbiologie qui est l'étude des microbes rassemble plusieurs spécialités qui étudient les bactéries, les virus, les parasites et les champignons microscopiques.
Parmi les spécialités de la microbiologie traitées par la biologie médicale on distingue : la bactériologie, la virologie, la parasitologie, la mycologie.

